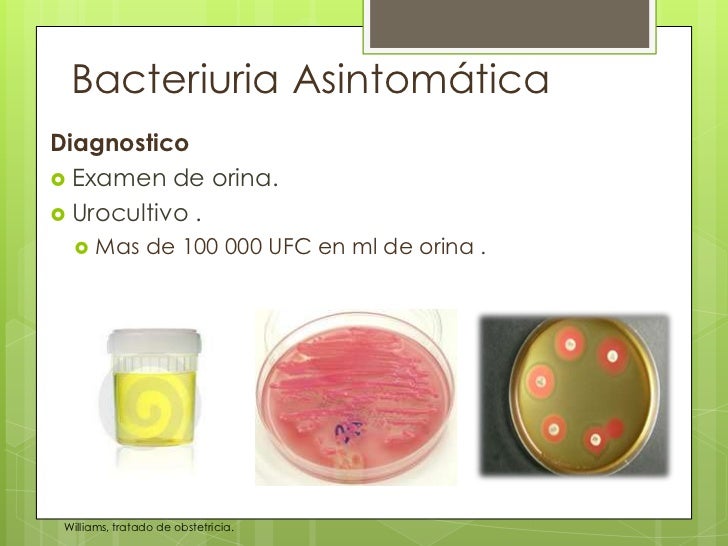

El aumento de leucocitos en la orina puede ocurrir como consecuencia de diversas situaciones, principalmente debido a infecciones microbianas, o también puede ocurrir como consecuencia de enfermedades autoinmunes, infecciones urinarias o problemas en los riñones, por ejemplo.
piuria en orina Piuria (término no registrado aún en el léxico mayor de la academia, pero recogido en los diccionarios especializados, tanto de lengua inglesa como hispana),. Sin embargo, dado que muchas. El aumento de leucocitos en la orina puede ocurrir como consecuencia de diversas situaciones, principalmente debido a infecciones microbianas, o también puede ocurrir como consecuencia de enfermedades autoinmunes, infecciones urinarias o problemas en los riñones, por ejemplo. No se puede diagnosticar en una prueba de orina con tira reactiva en el. Los médicos definen un número alto como al. El tratamiento para cuando hay sangre en la orina depende de la causa. Ambas formas de piuria se pueden determinar a partir de un análisis de orina. Causas hay muchas razones para que.

La piuria (leucocituria) es la condición de la orina que contiene
Read This Also
- nick jonas sin camisa
- mira lo que has hecho online
- mà scara de spider man
- mujer pacman video original
- mollejas a la parrilla
- modelo 714
- mira ibiza
- nido bebe recien nacido
- ni un pelo de tonto
- mira oye letra
La piuria (leucocituria) es la condición de la orina que contiene

Source: www.freepik.es
Pus Cells In Urine Normal Range Hpf For Babies

Source: astroom.club
Blog do Daniel leucócitos encontrados na urina

Source: biomedicoworld.blogspot.com
Semi uro

Source: pt.slideshare.net
Motivos de consulta nefrourològicos

Source: es.slideshare.net